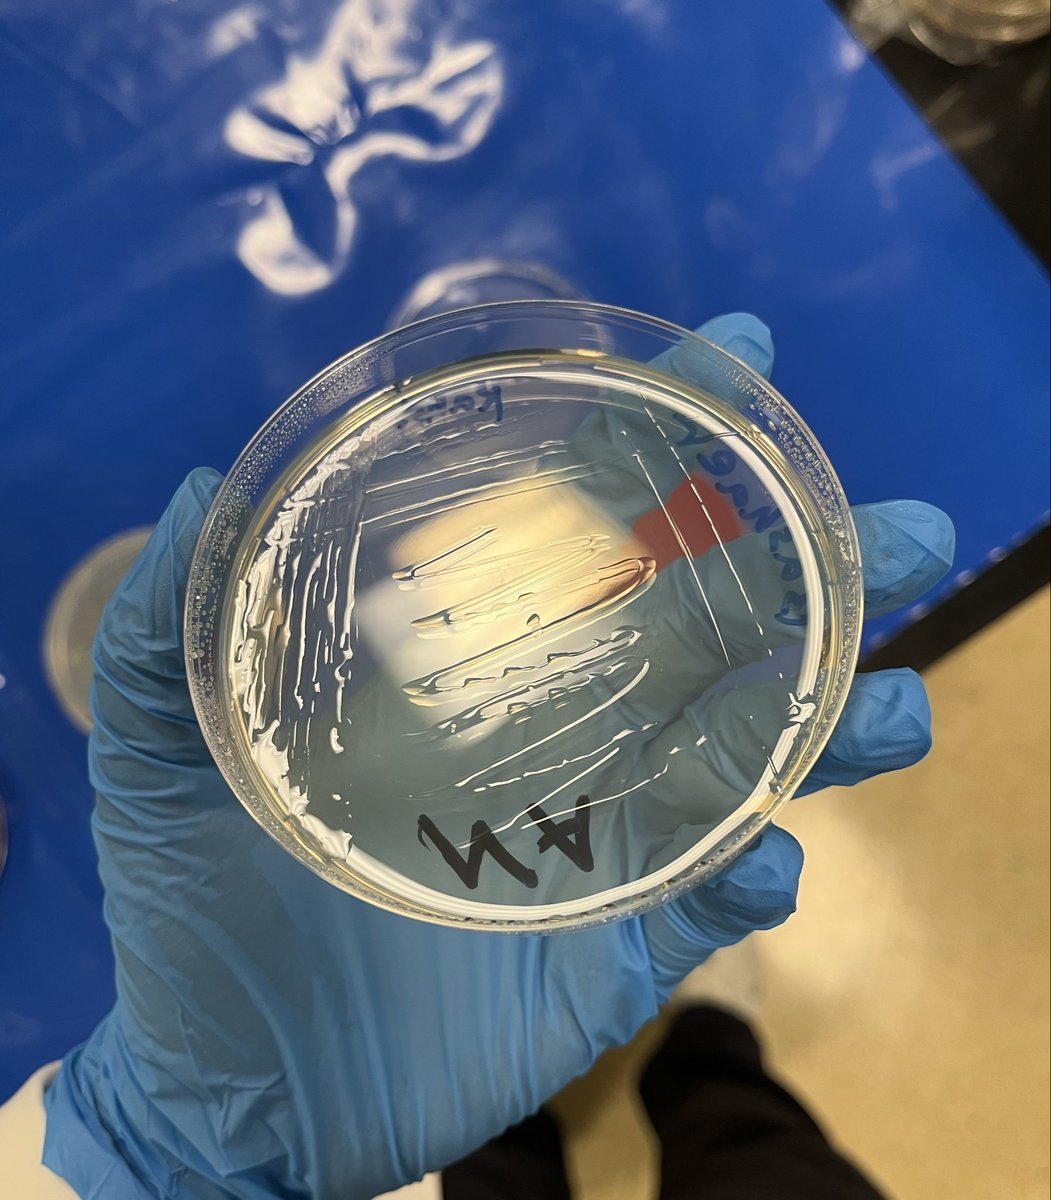
بـشائر 🇸🇦 tweet media
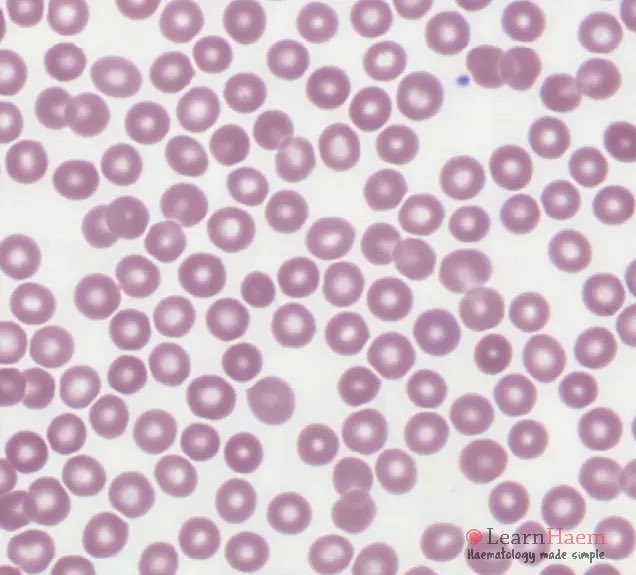
بـشائر 🇸🇦 tweet media

بـشائر 🇸🇦
927 posts


بـشائر 🇸🇦
@cls780
CLS student at @_KSU🔬, @CLS_Club
Riyadh Katılım Ağustos 2024
178 Takip Edilen313 Takipçiler

فعالية النادي الجاية شعارها الجين يقرر
احسبهم ينادوني x.com/minmuslslleemu…
العربية

بـشائر 🇸🇦 retweetledi

في غرفةٍ لا تحتمل التأخير، تُقاس الثواني بنبضة، وتتحوّل المؤشرات الحيوية إلى قراراتٍ مصيرية.
هناك يكشف القاتل الصامت عن وجهه، بين ألمٍ لا يُسمَع وخطرٍ يتسلّل دون إنذار.
ترقّبوا فعاليتنا القادمة #قلبك_أولًا، حيث نقترب من أمراض القلب وفحوصاتها… قبل أن يسبقنا الخطر بخطوة
#عالمٌ_يُرى_بعين_الفِكر
العربية

@ssdmls فيه ملاحظتين،
الأول، غالبًا انك مسويتها ب Pasteur pipette، وهالشيء يطلع لك كمية دم كثيره ما تعطيك تحكم كامل اذا سويتي لها Blood film والأصح انك تستخدمين Capillary tube.
الثاني، انك شايفتها من ال body والمفترض انك شايفتها من ال Tail عشان ما تصير ال RBCs فوق بعض ولا يوضح شكلها
العربية
بـشائر 🇸🇦 retweetledi
بـشائر 🇸🇦 retweetledi

@LabsterCLS طيب تدرين انك لو بلغتيها بالايميل انك ما بتجين ما بتحسب لك غياب🥰
العربية